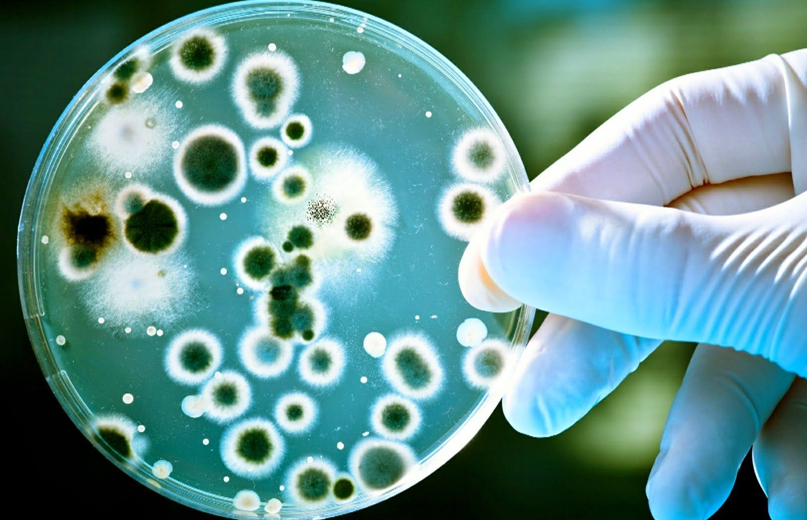

Yeni Test Merkezimiz Hizmete Girdi
Yeni test Merkezimiz Hizmete Girdi Alanında uzman personelden oluşan kadromuzla yeni ve modernt test hizmetleri sunuyoruz. Yeni Test merkezimizde onkoloji genetik ve moleküler genetik bilimleri alanında modern teknolojilerle hizmet veriyoruz. Genetik bilgi, vücuttaki her canlı hücrenin hücre çekirdeğinde bulunur. Bilginin örneğin bir kitapta saklandığı düşünülebilir. Bu kitabın genetik bilginin olduğu […]
Genetik Analiz Teknolojileri
Onkoloji Araştırmaları için Genetik Analiz Teknolojileri Moleküler tıp, uygun teşhis stratejileri ve hastalık müdahaleleri geliştirmek için hastalık patogenezinin altında yatan moleküler mekanizmaları anlamayı amaçlamaktadır. İmmüno-onkoloji alanında (araştırmacıların kanserle savaşmak için kanser hastasının kendi bağışıklık sisteminden yararlanmaya çalıştıkları), bir hastanın yanıt verip vermeyeceğini tahmin edebilecek potansiyel tanısal biyobelirteçleri, potansiyel terapötik hedefleri ve biyobelirteçleri […]
Moleküler Bilim ve Moleküler Tıp
Moleküler bilim ve Moleküler tıp Moleküler tıp, uygun teşhis stratejileri ve hastalık müdahaleleri geliştirmek için hastalık patogenezinin altında yatan moleküler mekanizmaları anlamayı amaçlamaktadır. Bu perspektiften bakıldığında, kimyagerler moleküler bilim insanları oldukları için, kimyagerler moleküler tıp alanında çok önemli bir rol oynayabilir ve oynamalıdır. 1949’da, uluslararası üne sahip kimyager Linus Pauling, Science dergisinde […]
COVID-19 Test Türleri
Koronavirüs (COVID-19) testlerinin türleri ve kullanımları Hangi tür testleri ve ne zaman kullanmanız gerektiği ve bir test sonucu aldığınızda ne yapmanız gerektiği dahil olmak üzere, farklı koronavirüs (COVID-19) testi türleri hakkında genel halk için rehberlik. Bir test yapmak genellikle bademciklerden (veya bulundukları yerden) ve burundan bir çubukla numune almayı içerir. […]
Mikrobiyoloji Tanımı
Mikrobiyoloji Mikrobiyoloji , mikroorganizmaların veya mikropların incelenmesi, bakteriler , arkeler , algler , mantarlar , protozoa ve virüsleri içeren genel olarak küçük basit yaşam formlarından oluşan çeşitli bir grup . Alan, bu tür organizmaların yapısı, işlevi ve sınıflandırılması ve faaliyetlerini hem kullanma hem de kontrol etme yolları ile ilgilenir . […]
Gen Nedir?
Gen nedir? Gen, kalıtımın temel fiziksel ve işlevsel birimidir. Genler DNA’dan oluşur. Bazı genler , protein adı verilen molekülleri yapmak için talimat görevi görür . Ancak birçok gen , proteinleri kodlamaz . İnsanlarda genlerin boyutları birkaç yüz DNA bazından 2 milyondan fazla baza kadar değişir. Genetik bilgi, vücuttaki her canlı hücrenin hücre çekirdeğinde bulunur. Bilginin örneğin bir kitapta saklandığı düşünülebilir. […]